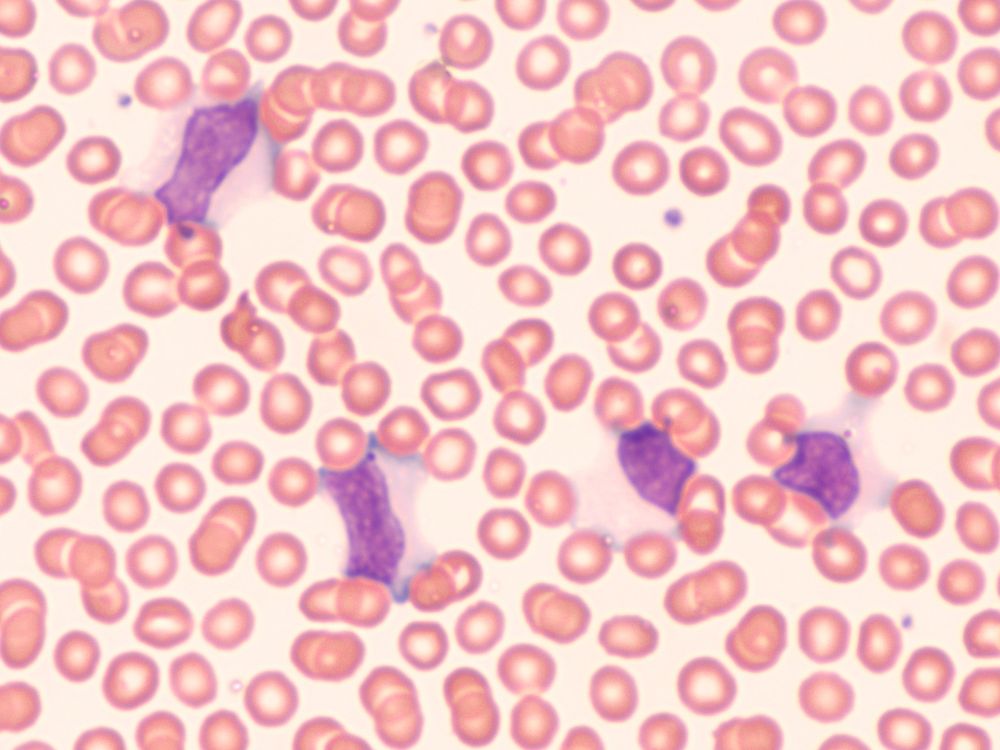

Mononucléose infectieuse : tout savoir sur cette maladie
Pharmacienne Titulaire
La mononucléose infectieuse, également appelée "maladie du baiser", est causée par le virus d'Epstein-Barr (EBV), de la famille des herpès virus. Si l'infection passe parfois inaperçue, elle cause la plupart du temps des symptômes proches de ceux de l'angine.
On estime que ce virus touche environ 50 % des enfants de 5 ans et 95 % des adultes. La maladie est souvent bénigne, quoiqu'elle puisse causer certaines complications (rupture de la rate, encéphalite, obstruction des voies respiratoires...). La Pharmacie des Drakkars vous explique tout sur la mononucléose !
Qu'est-ce que la mononucléose infectieuse ?
Très fréquente chez l'adolescent, cette maladie cause un syndrome mononucléosique sanguin qui va augmenter nombre d'éléments mononucléés dans le sang. Ceux-ci sont des cellules qui ne possède qu'un noyau, comme c'est le cas pour les lymphocytes et les leucocytes.
Après une période d'incubation comprise entre 4 et 7 semaines, la personne contaminée va commencer à ressentir les symptômes du virus, qui vont s'installer pendant une durée comprise entre 7 et 14 jours. Une fois guéri, le patient portera le virus toute sa vie mais aura acquis une immunité prolongée contre celui-ci.
Comment attrape-t-on la mononucléose infectieuse ?
La mononucléose infectieuse se transmet par contact direct ou par la salive. Le pic de contagion est atteint lorsque les symptômes sont les plus importants.
Une fois guéri, le patient pourra cependant continuer à transmettre la maladie pendant environ 6 mois.
Bon à savoir : l'exposition au virus d'Epstein-Barr (EBV) ne déclenche par forcément la maladie. Certaines personnes exposées à la mononucléose au cours de l'enfance n'ont présenté aucun symptôme et ont même développé des anticorps contre le virus.
Cependant, avec le développement de mesures d'hygiène de plus en plus importantes, on constate une baisse du nombre d'enfants immunisés contre cette infection.
Quels sont les symptômes de la mononucléose infectieuse ?
Vous avez de la fièvre ou encore des douleurs au niveau de la gorge ? Il peut en effet s'agir du virus de la mononucléose. Cette maladie se manifeste par le biais de différents symptômes :
une grande fatigue ; - une perte d'appétit ;
- des douleurs musculaires ;
- des maux de tête ;
- de la fièvre supérieure à 39 °C accompagnée de frissons ;
- une angine douloureuse ainsi que des difficultés à avaler ;
- l'apparition de rougeurs, de dépôts blancs et de membranes au niveau de la gorge ;
- des gonflements et douleurs au niveau des ganglions ;
- plus rarement, des plaques rouges sur le torse, les cuisses et les bras.
Si vous pensez souffrir d'une mononucléose infectieuse, parlez-en à votre médecin traitant. Il existe un test qui permet de détecter rapidement et efficacement l'infection.
Comment soigner la mononucléose infectieuse ?
Puisque la mononucléose infectieuse est une maladie virale, il n'existe pas de traitement parfaitement adapté. Cependant, pour soulager les douleurs et la fièvre, votre médecin vous prescrira probablement des antalgiques et des antipyrétiques. Le repos fait également parti intégrante du traitement.
Consultez de nouveau si vous ne constatez pas d'améliorations au bout de deux semaines, ou si de nouveaux symptômes inquiétants apparaissent, comme la jaunisse ou une faiblesse au niveau des membres, laissant penser à des complications de la mononucléose.
Vous avez des questions sur la mononucléose, sur le virus d'Epstein-Barr (EBV) ou encore sur les conséquences de l'infection ? Discutez-en avec un professionnel de santé !
AVERTISSEMENT : Ces propriétés, indications et modes d'utilisation vous sont proposés par l'équipe de la Pharmacie des Drakkars. Ils sont souvent tirés de notre expertise ainsi que d'ouvrages et sites Internet de référence et sont en majeure partie confirmés par des observations en milieu scientifique. Toutefois, ces informations sont données à titre informatif et ne sauraient en aucun cas constituer une information médicale, ni engager notre responsabilité. Au moindre doute ou pour tout usage des huiles essentielles, des hydrolats et des plantes, consultez un médecin.